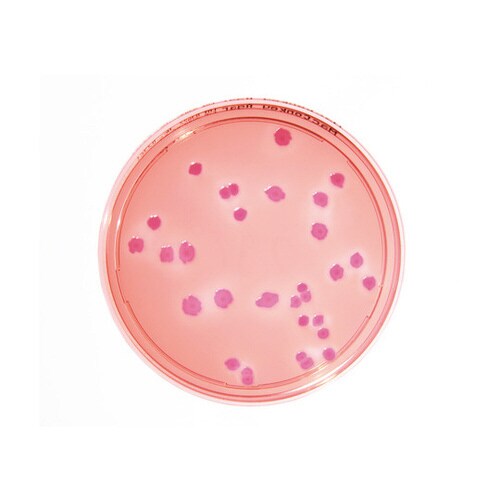
微生物試験培地1.46022.0020

分析/検査用品の売れ筋ランキング
- ¥606(税込) (税込) 〜
- ¥491(税込) (税込) 〜
- ¥438(税込) (税込) 〜
- ¥4,510(税込) (税込) 〜
5位
pH試験紙 ロールタイプ
- ¥1,881(税込) (税込) 〜
- ¥10,972(税込) (税込) 〜
- ¥3,487(税込) (税込) 〜
商品の特徴 |
日本薬局方適合の生培地です。 |
|---|---|
商品仕様 |
|
メーカー情報 |
|
カタログ掲載ページ |
-/- |
| 注意事項 | ※【返品に関するご注意】この商品は直送品のため、お客様のご都合による返品はお受けできません。 |
|---|